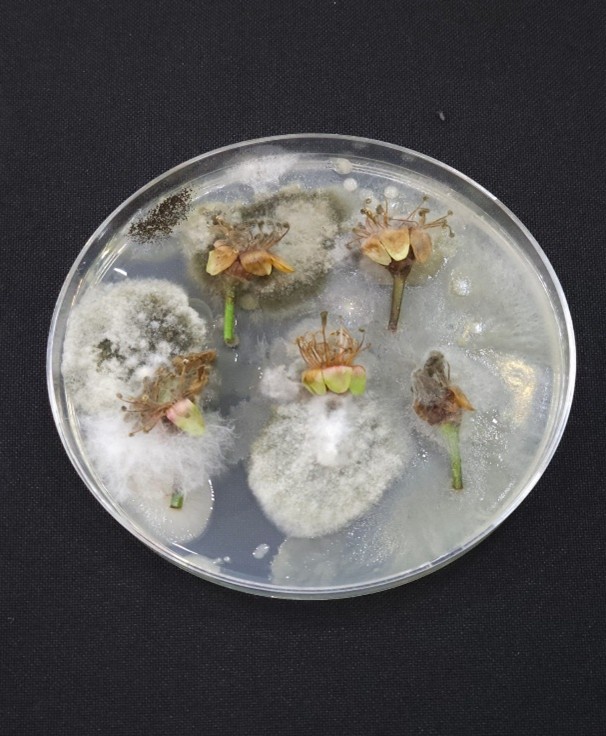

Últimos Artículos
Condiciones Climáticas y su Impacto en la Incidencia de Enfermedades en pre y poscosecha de cerezos
Durante la etapa de floración del cerezo en las zonas centro y centro-sur del país, se han registrado condiciones climáticas poco favorables para el desarrollo del cultivo. La ocurrencia de precipitaciones, seguida de períodos con temperaturas elevadas, ha favorecido al aumento de la incidencia de enfermedades, particularmente cáncer bacterial (Pseudomonas syringae pv. syringae) y diversas patologías de origen fúngico que afectan directamente la floración y cuaja del fruto.

Análisis de fertilidad de yemas Carozos
En nuestro laboratorio LAGRIC ya comenzamos con el análisis de fertilidad de yemas en carozos (cerezos y ciruela d`agen). Este análisis permite identificar cuántas yemas son verdaderamente productivas, entregando información valiosa para planificar una poda estratégica y ajustar la carga frutal en función del potencial real del cultivo.

Manual «Transferencia de estrategias de optimización del riego por goeto en: ciruelo japonés (Prunus salicina L.) y nectarino (Prunus persica var. nucipersica L.) mediante la utilización de mulch plástico»
Les compartimos el manual "Transferencia de estrategias de optimización del riego por goteo en ciruelo japonés y nectarino mediante la utilización de mulch plástico", desarrollado en el marco del proyecto ejecutado por el CER y financiado por el Gobierno Regional de O'Higgins.

Optimización del riego para un futuro sostenible en la fruticultura
Compartimos la ficha técnica "EQUIPOS DE MONITOREO DEL ESTADO HÍDRICO EN PLANTAS DE CIRUELO JAPONÉS Y NECTARINO" del proyecto FIC,"Transferencia de estrategias de optimización del riego por goteo mediante la utilización de mulch plástico

Optimización del agua y manejo sustentable en la producción de cucurbitáceas en O’Higgins
Compartimos la encuesta "Caracterización del tipo de tecnologías de riego disponibles y el uso de plástico en la producción de cucurbitáceas en la región de O'higgins".

